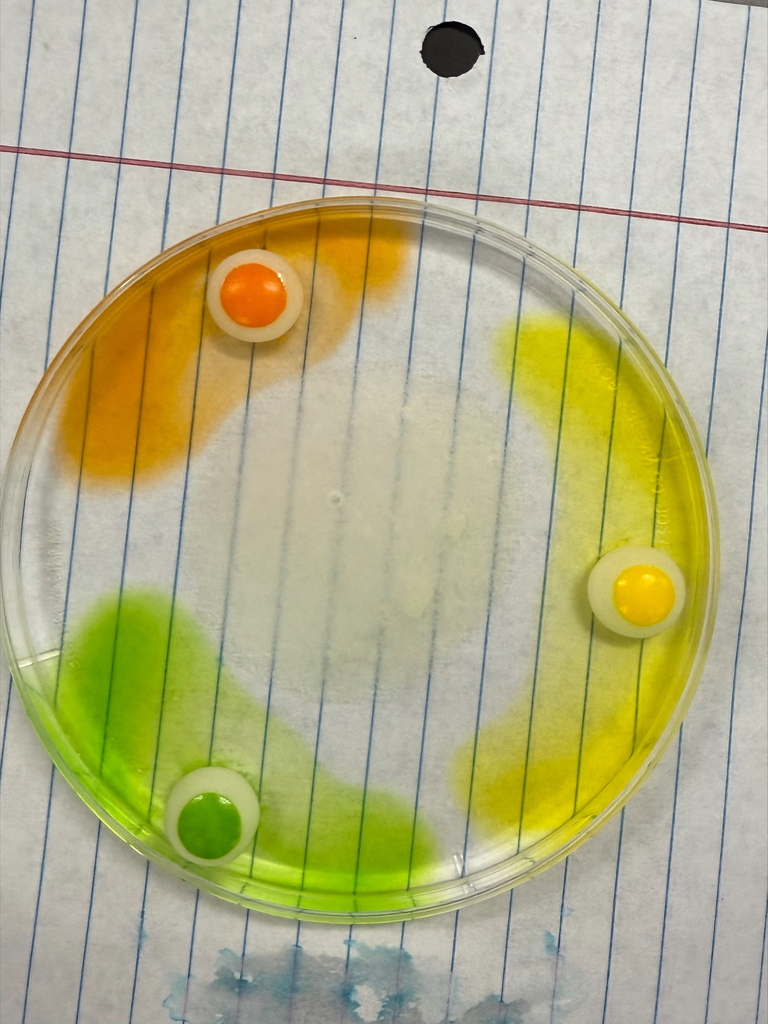

Our Tigers put their Spanish skills to the test by writing, memorizing, and performing original skits — completely in Spanish! From creativity to confidence, they nailed all four skills: reading, writing, listening, and speaking. 🌟
Swipe through to see their amazing performances and the fun happening in Señorita McDole's classroom! 🧡🖤
#WLSTigers #TigerPride #SpanishClass #LanguageLearning #WLSSpanish #TigersLearn









The West Liberty-Salem Boys Cross Country Team continues to set the bar high in the Ohio Heritage Conference! We’re proud to recognize these outstanding athletes for their accomplishments this season.
🥇 OHC Runner of the Year
• Senior Caleb Larson
🏆 Special congratulations to Senior Caleb Larson for winning back-to-back individual OHC titles!
Caleb’s blazing 15:41.0 finish set a new OHC course record, surpassing alumni Dylan Lauck’s 2020 record of 15:42.4!
💪 1st Team All-OHC
• Caleb Larson
• Asher Cole (So.)
• Dylan King (Sr.)
• Brayan Gullett (So.)
• Garrett Wallen (Sr.)
🔥 2nd Team All-OHC
• Zeke Longshore (So.)
• Owen Hardwick (So.)
🏅 Honorable Mention All-OHC
• Eric Hoover (Fr.)
• Gauge Lee (So.)
Congratulations to these Tigers for their dedication, leadership, and exceptional performances all season long! Your hard work continues to uphold the proud tradition of excellence in WL-S Cross Country. 🐾
#TigerPride #WLSTigers #AllOHC #CrossCountryDominance #BackToBackChampion










We’re proud to recognize our outstanding Lady Tiger Cross Country runners for their achievements in the Ohio Heritage Conference this season!
🥇 1st Team All-OHC
• Malia Miller
• Addi Wallen
🥈 2nd Team All-OHC
• Gwen McCullough
• Isla Leichty
• Elia Matthews
🏅 Honorable Mention All-OHC
• Mariska Smith
• Charlee Albers
These athletes have shown incredible dedication, teamwork, and Tiger Pride throughout the season. Congratulations to all on representing West Liberty-Salem with excellence both on and off the course! 🐾
#TigerPride #WLSTigers #AllOHC #CrossCountryStrong








Congratulations to Emma Smith and Dylan King, our West Liberty-Salem High School October Seniors of the Month! 🧡🖤
Each month, West Liberty-Salem High School recognizes two seniors who demonstrate leadership, character, academic excellence, and a commitment to making a positive impact on our school and community.
Emma and Dylan are outstanding examples of what it means to be a Tiger — hardworking, kind, and involved in so many ways both in and out of the classroom. Their dedication and spirit help make WL-S a place we’re proud to call home.
Please join us in celebrating these two incredible students and congratulating them on this well-deserved honor! 👏 To read more visit:
https://westlibertysalemoh.sites.thrillshare.com/documents/student-life/seniors-of-the-month/2025-26/october/858447
#WLSTigers #TigerPride #SeniorOfTheMonth #WLSClassof2025



Tomorrow night, the newly formed WLS Jazz Band will take the stage for their first official performance at 7:30 PM in the West Liberty Opera House! 🎷🎺🥁
This talented group has been working hard to master new sounds and styles—from classic big band favorites of the 1930s and 40s to modern jazz tunes you’ll recognize. You’ll hear a wide variety of upbeat, toe-tapping pieces that showcase just how much these students have learned in a short time.
Come out and support these amazing Tigers as they bring great music and energy to our community! 🧡🖤
#WLSTigers #TigerPride #WLSJazzBand #LiveMusic #WestLibertyOperaHouse


This week, we proudly recognize and thank our West Liberty-Salem Board of Education for their dedication, leadership, and commitment to our students, staff, and community.
Our Board members give countless hours to ensure the success of every Tiger — guiding decisions that impact academics, facilities, extracurriculars, and the overall student experience. Their vision and service help make WL-S a place where excellence and opportunity thrive.
👏 Please join us in expressing our appreciation to our Board of Education for their ongoing efforts to keep our district moving forward with #TigerPride!
West Liberty-Salem School Board Members:
Ryan Cole, Tim Lamb-Vice President, Amy Pratt, Doug Williams, Pat Adams-President
If you'd like to learn more about our Board of Education, visit https://www.wlstigers.org/page/board-of-education
#WLSTigers #TigerPride #BOERecognitionWeek #ThankYouBOE


We’re proud to recognize our West Liberty-Salem Tiger golfers who were honored by the Ohio Heritage Conference for their strong seasons on the course!
🏆 Sutton Wilcoxon – 2nd Team All-OHC
✨ Braydon Thompson – Honorable Mention All-OHC
✨ Troy Christison – Honorable Mention All-OHC
These athletes represented the Tigers with skill, composure, and sportsmanship throughout the season. Congratulations, golfers, on an outstanding year! 🐾
#TigerPride #WLSTigers #OHCGolf #AllOHC #TigersGolf




Using Skittles as their model system, students investigated how temperature and sugar concentration affect the movement of dye molecules through water. Through careful prediction, observation, and analysis, they witnessed how molecules naturally move from areas of higher concentration to lower concentration — a fundamental concept in biology.
This vibrant investigation not only brought textbook concepts to life but also encouraged critical thinking, scientific inquiry, and collaboration in the classroom. Way to go, future scientists! 🍬🧠
#TigerPride #ScienceInAction #HandsOnLearning

Last week, our Mock Trial Team took an unforgettable trip to the State of Ohio Supreme Court in Columbus! Students explored the historic building, learned about the judicial system, and discussed real-world issues facing Ohio’s government.
Faculty advisor Sean Stormes shared, “This visit was an incredible opportunity for our students to connect what they’ve learned in the classroom to the real workings of Ohio’s legal system.”
The team is now hard at work preparing for their upcoming case, The State of Buckeye vs. Morgan Remy, which they’ll present at the District Competition on January 30, 2026.
Read the full story here: https://www.wlstigers.org/article/2482948
#TigerPride #MockTrial #OhioSupremeCourt #FutureLeaders







Our 7th grade Advanced Science students are putting their creativity and problem-solving skills to the test! Some are competing to see who can build the strongest electromagnet, while others are designing and constructing the loudest siren using Snap Circuits.
Hands-on experiments like these bring science concepts to life and challenge students to think critically, test hypotheses, and learn through discovery — all while having fun in the process!
#TigerPride #STEMLearning #HandsOnScience #InnovationInAction






🏐 Congratulations to our All-OHC Volleyball Honorees! 🧡🖤
We’re so proud of our West Liberty-Salem Tigers who were recognized by the Ohio Heritage Conference for their outstanding seasons, leadership, and sportsmanship:
🏆 Naomi Cole – OHC Player of the Year
✨ Ava Poppe – 2nd Team All-OHC
✨ Reagan Winters – Honorable Mention All-OHC
✨ Lyndee Harrison – Honorable Mention All-OHC
🤝Kiersten Stoll – OHC Sportsmanship Award
These athletes represented Tiger Volleyball with talent, heart, and class all season long. Congratulations to each of you on your well-deserved honors! 🐾
#TigerPride #WLSTigers #AllOHC #OHCVolleyball #TigersVolleyball






Fall sports are wrapping up and now is the time to sign up for the WL-S High School Varsity Swim Team. Sign ups are due by October 24th. Email Kraig Hissong at khissong@wlstigers.org or call (937) 465-1075 x115 if you have questions. Enjoy a two week trial to see if swimming is right for you. There are many benefits of swimming for strength and conditioning and swimming is a fun way to compete. Meets are designed so that swimmers swim against competition at their same skill level. So grab your swimsuit and see what swim stroke is your favorite!




We’re celebrating our students who go above and beyond—showing kindness, respect, responsibility, and that true Tiger Pride every single day! 🧡🐾
Congratulations to last week’s Gold Card winners for setting the example and making our school a better place to learn and grow. Your hard work, positive attitude, and great choices don’t go unnoticed! 🙌
In Elementary.
Tahlia Buck
Kyla Fischer
Lincoln Coder
Charlie Stanford
Landry Woodruff
Mason Wright
Gwen Williams
Tori Moffit-Greene
Charlotte Terry
Adalee Rutherford
Malachi Fiorini
Kole McIntosh
Khloe Miller
Griffin Kimball
Lance Studebaker
Piper Smith
Thomas Williams
Joel Booze
Lakelynn Roberts
Catie Dagger
Bexley Middleton
Layla Ulmer
Ian Shoemaker
Imajene Meister
Millie Humphrey
In Middle School:
6th Grade – Saige Thompson given by Mrs. Unger
7th Grade – Katie Moxley given by Mrs. Mazza
8th Grade – Jude Roberts given by Mrs. Phelps
In High School:
9th Mia Dooley – given by Mrs. Harman
10th Gavin Bell – given by Mr. Sidders
11th Xzavior Nicholl – given by Mrs. Nieman
12th Kaylee Powell – given by Mrs. Havens
#GoldCardFriday #TigerPride #WLSTigers #CharacterCounts


It’s a big week for the Tigers — tournament season has arrived for our Volleyball, Soccer, and Cross Country teams! 🏐⚽🏃♀️ Come out and support our student-athletes as they compete in postseason play and represent WL-S with pride!
And don’t forget — Tiger Football is still rolling through the regular season, gearing up for another big Friday night under the lights! 🏈🔥
Check out where you can catch all the action this week and help us pack the stands with orange and black!








🎶 Marching Tiger Band Heads to Ohio State! 🧡🖤
The West Liberty-Salem Marching Tiger Band will take the field at Ohio Stadium this Saturday, October 11, as part of the OSU Band Invitational!
Our Tigers are scheduled to perform at 11:45 AM, joining bands from across the state for a full day of incredible performances.
🎟 Tickets:
$20 if purchased ahead of time at go.osu.edu/bi2025
$25 at the gate (exact change only)
After our WL-S performance, guests can enjoy performances from other bands throughout the day, with the Ohio State University Marching Band taking the field at 9 PM, followed by awards.
Let’s cheer on our Marching Tigers as they represent WL-S with pride at The Shoe! 🎺🐾

The 2025 Hall of Fame will honor John Roettger with the Contributor Award, recognizing his outstanding leadership and unwavering support of Tiger athletics and education.
Roettger served as Superintendent of West Liberty-Salem Schools from 1994–2000, a time marked by growth, facility improvements, and strong community collaboration. His steady leadership helped position the district for continued success. Following his tenure, he continued to serve as a Board of Education member from 2002–2005, ensuring the district’s mission and values remained strong.
His involvement reached beyond administration—Roettger also coached Freshman Girls Basketball from 2000–2002, where he invested in developing student-athletes and fostering teamwork. His passion for WL-S was evident in every role he held, always placing students and their experiences at the heart of his work.
🧡 Congratulations, Mr. Roettger, on your well-deserved induction, and thank you for your lasting impact on Tiger athletics and the West Liberty-Salem community! 🖤
Hall of Fame Inductees will be recognized between the 1st & 2nd quarter of tonight's football game following an informal reception at 6:00 PM, in the courtyard across from the Stadium.


Didn't buy a 24-25 yearbook? This is your chance! We have 15 extra copies up for grabs. $45 cash or check made payable to WL-S.


